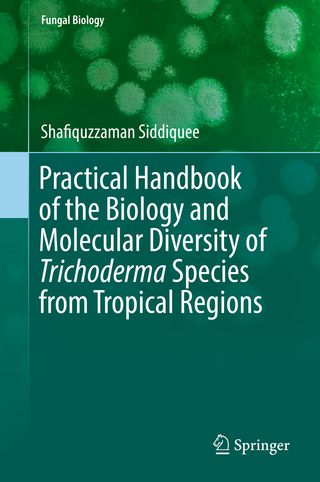
Practical Handbook of the Biology and Molecular Diversity of Trichoderma Species from Tropical Regions

Genes, genomes, and evolution
eBook Download (EPUB)
2017
|
OUP Oxford
ISBN: 9780192535771
66,09 €
(CHF 64,55) (inkl. MwSt)
(CHF 64,55) (inkl. MwSt)
- Download sofort lieferbar